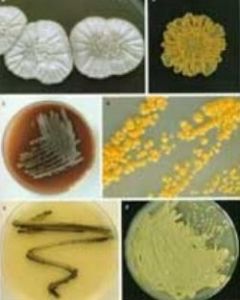
菌落

概述
菌落
菌落菌落是指單個細菌(或其它微生物)細胞在固體培養基表面或內部生長繁殖而形成的有一定形態結構等特徵的能被肉眼識別的子細胞群落,它是由數以萬計相同的微生物細胞集合而成的。當菌種樣品被稀釋到一定程度,與培養基混合,在一定培養條件下,每個能夠生長繁殖的細菌細胞都可以在平板上形成一個可見的菌落。
菌落總數是指在一定條件下(如培養基營養成分、培養基pH、培養溫度和時間、菌種的需氧性等)每克(每毫升)檢樣所生長出來的細菌菌落總數。按照國家標準方法規定,在需氧情況下,37℃培養48h,能在普通營養瓊脂平板上生長出來的細菌菌落總數,厭氧菌或微需氧菌、有特殊營養要求的以及非嗜中溫的細菌,由於現有條件不能滿足其生理需求,故難以繁殖生長。因此菌落總數並不表示實際中的所有細菌總數。菌落總數並不能區分其中的細菌種類,因此它們有時被稱為雜菌數或需氧菌數等。
菌落形成單位(colony forming unit,CFU)是計算菌落數量的一種方法,其值越高表示樣品所含的細菌越多。菌落形成單位的計量方式與一般的計數方式不同,一般直接在顯微鏡下計算細菌數量時會將活的與死的細菌全部算入,但是CFU只計算活的細菌,其計算的方式是將一份樣本接種到瓊脂培養基上,待菌落生成,計算形成的菌落數。
作用
菌落總數測定常用來判定食品被細菌污染的程度及衛生質量,它反映食品在生產過程中是否符合衛生要求,以便對被檢樣品做出適當的衛生學評價。菌落總數的多少在一定程度上標誌著食品衛生質量的優劣。
檢測方法
菌落總數的測定,一般是將被檢樣品製成幾個不同的10倍遞增稀釋液,然後從每個稀釋液中分別取出1mL置於滅菌平皿中與營養瓊脂培養基混合,在一定溫度下,培養一定時間後(一般為48小時),記錄每個平皿中形成的菌落數量,依據稀釋倍數,計算出每克(或每毫升)原始樣品中所含細菌菌落總數。
基本操作
 菌落總數測量方法
菌落總數測量方法基本操作一般包括:樣品的稀釋--傾注平皿--培養48小時--計數報告。
國內外菌落總數測定方法基本一致,從檢樣處理、稀釋、傾注平皿到計數報告無明顯不同,只是在某些具體要求方面稍有差別,如有的國家在樣品稀釋和傾注培養基時,對吸管內液體的流速,稀釋液的振盪幅度、時間和次數以及放置時間等作了比較具體的規定。
具體操作步驟
樣品的處理:(1)以無菌操作取檢樣25g(或25ml),放於225mL滅菌生理鹽水或其他稀釋液的滅菌玻璃瓶內(瓶內預置適當數量的玻璃珠)或滅菌乳缽內,經充分振搖或研磨製成1:10的均勻稀釋液。
(2)固體檢樣在加入稀釋液後,最好置滅菌均質器中以8000~10000r/min的速度處理1min,製成1:10的均勻稀釋液。
(3)用1ml滅菌吸管吸取1:10稀釋液1ml,沿管壁徐徐注入含有9ml滅菌生理鹽水或其他稀釋液的試管內,振搖試管混合均勻,製成1:100的稀釋液。
傾注培養:
(1)根據標準要求或對污染情況的估計,選擇2~3個適宜稀釋度,分別在制10倍遞增稀釋的同時,以吸取該稀釋度的吸管移取1ml稀釋液於滅菌平皿中,每個稀釋度做兩個平皿。
 裸露售賣是造成菌落總數超標的原因之一
裸露售賣是造成菌落總數超標的原因之一(2)將約15ml涼至46℃營養瓊脂培養基注入平皿,並轉動平皿,混合均勻。同時將營養瓊脂培養基傾入加有1ml稀釋液(不含樣品)的滅菌平皿內作空白對照。
(3)待瓊脂凝固後,翻轉平板,置36±1℃溫箱內培養48±2h,取出計算平板內菌落數目,乘以稀釋倍數,即得每克(每毫升)樣品所含菌落總數。
計數和報告:
培養到特定時間後,計數每個平板上的菌落數。可用肉眼觀察,必要時用放大鏡檢查,以防遺漏。在記下各平板的菌落總數後,求出同稀釋度的各平板平均菌落數,計算出原始樣品中每克(或每毫升)中的菌落數,進行報告。
注意事項:
(1)操作要快而準,包括材料、加樣、倒培養基。
(2)吸液體時液體不能進入吸頭。
(3)樣品稀釋時一定要混勻。
(4)倒培養基前,瓶口要過火焰。
(5)一定要有空白對照。
(6)培養基溫度,培養基薄厚應控制好。
(7)檢測時一定要使平皿完全暴露於空氣中。
超標危害
食品的菌落總數嚴重超標,說明其衛生狀況達不到基本的衛生要求,將會破壞食品的營養成分,加速食品的腐敗變質,使食品失去食用價值。消費者食用微生物超標嚴重的食品,很容易患痢疾等腸道疾病,可能引起嘔吐、腹瀉等症狀,危害人體健康。
但需要強調的是,菌落總數和致病菌有本質區別,菌落總數包括致病菌和有益菌,對人體有損害的主要是其中的致病菌,這些病菌會破壞腸道里正常的菌落環境,一部分可能在腸道被殺滅,一部分會留在身體裡引起腹瀉、損傷肝臟等身體器官,而有益菌包括優酪乳中常被提起的乳酸菌等。但菌落總數超標也意味著致病菌超標的機會增大,增加危害人體健康的幾率。
室內細菌菌落總數標準
室內空氣污染中,關於菌落總數的控制,國家標準細菌菌落總數≤2500cfu/m3。室內細菌菌落總數的來源
室內建築材料:在室內潮濕、結露的地方或受水侵害的地方,環境的相對濕度高達90%-100%,室內的建築材料和設備,就必然容易孳生細菌和真菌等微生物,特別是真菌,這是個普遍存在的問題。由於空氣流動,導致在建築材料和設備中的真菌氣溶膠化,懸浮於空氣中,造成室內空氣污染。家用設備:室內的家用設備如空調器和加濕器中也容易孳生細菌和真菌等微生物,成為室內空氣微生物潛在污染源。家用空調器在製冷時,內部結露,相對濕度接近100%,適合細菌和好濕性真菌孳生繁殖;空調器的過濾器、進風和排風口的相對濕度約在70%-90%,適合中濕性真菌和好於性真菌生長。
消除室內菌落總數超標的方法
硅藻泥的組織結構是一種多孔的“分子篩”狀,在此基礎上,加強負氧離子的釋放,負氧離子在空氣中浮游,有極強的殺菌能力,抑菌率在92%以上。像對大腸肝菌有94.5%的抑制率金黃葡萄桿菌95.5%的抑制率。獨具的“分子篩”作用和選擇性吸附性能,可以明顯減少動物體臭以及吸菸、廚房衛生間生活垃圾等所產生的空氣異味,消除室內空氣污染菌落總數超標所帶來的危害,改善起居環境。超標事件
 桶裝水曾有過大批超標事件
桶裝水曾有過大批超標事件2009年8月,河南省鄭州市食品藥品安全委員會辦公室公布樂百氏薄荷水菌落總數超標。
2009年10月,國家質檢總局網站公布了對200種豆製品產品的抽查結果,有18款產品不合格登上了“黑名單”,其中,“川妹子”鹵香豆乾菌落總數超過標準限量近70倍。
2010年8月,國家質檢總局進出口食品安全局公布一批次進口自美國的“品客”薯片被發現菌落總數超標。
2010年10月,天津市工商行政管理局公布標稱鄭州上好佳食品工業有限公司“上好佳”谷維精華綠茶餅乾菌落總數超標。
2011年6月,國家質檢總局公布山西娃哈哈昌盛飲料有限公司生產的白葡萄汁飲品菌落總數超標。
2011年8月,北京全市停售“雨潤”老北京烤鴨、“福聚興”烤鴨、“大東老曹”牌烤鴨等4種菌落總數超標產品。
2011年10月,北京市食品安全辦公室公布北冰洋雙把雪糕因菌落總數超標停售。
2011年11月,蒙牛“隨變榛子朱古力雪糕”在“菌落總數、大腸菌群”兩個重要微生物指標中超標。
2011年12月,深圳市場監督管理局公布包括“煌上煌”、“絕味”、“周黑鴨”等知名品牌熟制鴨脖的大腸菌群和菌落總數超標。
2012年1月,波力食品工業(崑山)有限公司生產的“波力海苔”(11.2g/包調味紫菜)被檢測出菌落總數超標。
2012年1月,北京市食品安全辦公室公布老才臣家庭裝火鍋調料火鍋蘸料菌落總數超標5倍有餘。
2012年1月,食品安全監管部門抽檢“滿記甜品”出售的芒果布丁因大腸桿菌超標近3倍,菌落總數超標13倍被下架。
2012年4月,北京市食品安全辦通報,“恆翔”鄉巴佬麻辣美味香乾,因菌落總數實測值是標準值的26倍而停售。並且已購買不合格食品的消費者,可憑購物小票和食品外包裝向銷售單位退貨。
2012年4月,上海市食品安全委員會辦公室通報,上海虹口糕團食品廠生產的青團(300克/袋)、上海麥園食品廠生產的“麥園”艾草糕團(250克/包)、上海華榕食品有限公司生產的“阿呆閒品”青團(計量稱重)、上海三香食品有限公司食品廠生產的“萬壽齋”青米糰(400克/盒)的菌落總數超標,已停止銷售。
2012年7月23日,光明乳業再曝乳品菌落超標,並表示,菌落總數超標的原因為長途運輸過程中擠壓受損、加上銷售環境的溫度不穩定所致。
2012年9月,網傳戴耳機等於養細菌,專家證明戴耳機會加速細菌繁殖,導致菌落總數超標,耳機應常消毒。
2013年7月21日,央視記者在崇文門的肯德基、真功夫和麥當勞3家大型快餐店中,取回可食用冰塊進行抽樣檢測。檢測結果卻顯示,3家快餐店的大腸菌群、金黃色葡萄球菌以及沙門氏菌群均符合國家標準,而菌落總數則超標。

